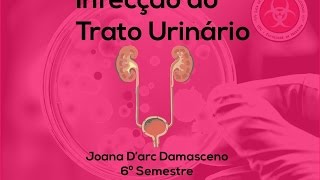
Infecção do Trato Urinário

Unknown
0 views2 WordsCopy TextShare
Unknown
Video Transcript:
No transcript available.
Related Videos

13:44
Infecção do trato urinário (ITU) - Aula MR
Medicina Resumida
31,126 views

13:41
Infecção urinária em idosos: Especialista ...
Mundo da Infectologia
11,323 views

47:12
ITU - INFECÇÃO DO TRATO URINÁRIO
Tv Saúde Brasil
7,899 views

2:19
Pielonefrite: o que é? | Dr. Cassio Andreo...
Dr. Cassio Andreoni
30,646 views

19:26
Infecção do trato urinário (ITU) - Aula de...
Medicina Resumida
63,518 views

34:26
EXAME DE URINA: tire todas suas dúvidas
Dr. Samuel Dalle Laste
22,682 views

3:29
Principais Medidas de Prevenção de Infecçã...
HospitalMoinhos
42,716 views

7:08
How to Relieve Urinary Tract Infection IMM...
Dr. Petronio Melo - Urologista
395,689 views

25:13
Pielonefrite: o que é, causas, sintomas e ...
IBAP Cursos
22,140 views

1:00:44
ITU - Aprenda a conduzir adequadamente
Médico na Prática
21,820 views

36:53
Infecção do Trato Urinário (ITU) | Super R...
Estratégia MED
45,566 views

19:43
Prevenção de Infecção do Trato Urinário
Coren SP
3,207 views

23:42
IRAS - Infecção Realaciona a Assistência ...
Enfermagem Nua e Crua
6,835 views

11:13
10 Things Cats HATE More Than Being PICKED...
The Curious Cat
79,333 views
![Sintomas da Infecção Urinária [SINAIS PERIGOSOS]](https://img.youtube.com/vi/WbjB2vvQ-T0/mqdefault.jpg)
10:12
Sintomas da Infecção Urinária [SINAIS PERI...
Nutricionista Patricia Leite
643,101 views

15:36
Infecção do Trato Urinário – Manejo Clínico
Eu Médico Residente
5,552 views

14:42
10 Cuidados de Enfermagem ao Paciente com AVC
Chama o Enfermeiro
58,187 views

13:42
COMO FAZER PARA A SONDA NÃO INFECTAR? INFE...
Descomplica Enfermagem
31,922 views

6:57
TRATAMENTO DA PIELONEFRITE - INFECÇÃO URIN...
Facilitando a Medicina
13,180 views
52:50
Infecção do Trato Urinário
LEDI-UFC
9,942 views